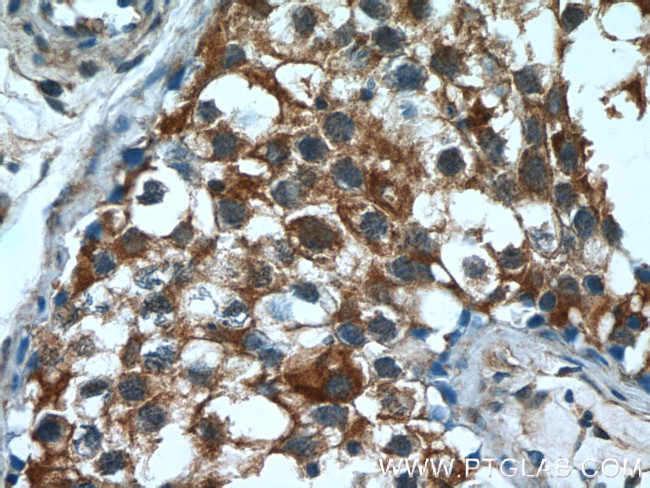
PUMA Antibody in Immunohistochemistry (Paraffin) (IHC (P))
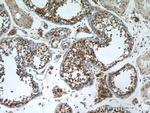
PUMA Antibody in Immunohistochemistry (Paraffin) (IHC (P))

Search
Proteintech
PUMA Polyclonal Antibody
{{$productOrderCtrl.translations['antibody.pdp.commerceCard.promotion.promotions']}}
{{$productOrderCtrl.translations['antibody.pdp.commerceCard.promotion.viewpromo']}}
{{$productOrderCtrl.translations['antibody.pdp.commerceCard.promotion.promocode']}}: {{promo.promoCode}} {{promo.promoTitle}} {{promo.promoDescription}}. {{$productOrderCtrl.translations['antibody.pdp.commerceCard.promotion.learnmore']}}
产品信息
55120-1-AP
种属反应
已发表种属
宿主/亚型
分类
类型
抗原
偶联物
形式
浓度
规格
纯化类型
保存液
内含物
保存条件
运输条件
产品详细信息
55120-1-AP can recognize PUMA alpha 21-24 kDa and PUMA beta 15-18 kDa.
靶标信息
PUMA is one of the pro-apoptotic Bcl-2 family members including Bax and Noxa, which are also transcriptional targets of p53. The PUMA gene encodes two BH3 domain-containing proteins termed PUMA-a and PUMA-b. PUMA proteins bind Bcl-2, localize to the mitochondria, and induce cytochrome c release and apoptosis in response to p53. PUMA may be a direct mediator of p53-induced apoptosis. Antisense inhibition of PUMA expression reduced the apoptotic response to p53, and PUMA is likely to play a role in mediating p53-induced cell death through the cytochrome c/Apaf-1-dependent pathway.
仅用于科研。不用于诊断过程。未经明确授权不得转售。
生物信息学
蛋白别名: Bcl-2 binding component 3; Bcl-2-binding component 3; Bcl-2-binding component 3, isoforms 1/2; Bcl-2-binding component 3, isoforms 3/4; BH3-only; FLJ42994; JFY-1; p53 up-regulated modulator of apoptosis; p53-induced BH3-only protein; p53-upregulated modulator of apoptosis; unnamed protein product
基因别名: BBC3; JFY-1; JFY1; PUMA; PUMA/JFY1
UniProt ID: (Human) Q96PG8, (Rat) Q80ZG6, (Mouse) Q99ML1
Entrez Gene ID: (Human) 27113, (Rat) 317673, (Mouse) 170770